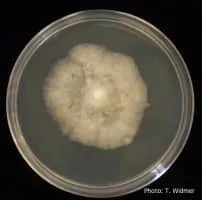
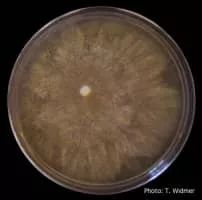

Phytophthora Palmivora
| Use attributes for filter ! | |
| Class | Oomycota |
|---|---|
| Scientific name | Phytophthora palmivora |
| Order | Peronosporales |
| Rank | Species |
| Higher classification | Phytophthora |
| Family | Peronosporaceae |
| Date of Reg. | |
| Date of Upd. | |
| ID | 1218907 |
About Phytophthora Palmivora
Phytophthora palmivora is an oomycete that causes bud-rot of palms, fruit-rot or kole-roga of coconut and areca nut. These are among the most serious diseases caused by fungi and moulds in South India. It occurs almost every year in Malnad, Mysore, North & South Kanara, Malabar and other areas.